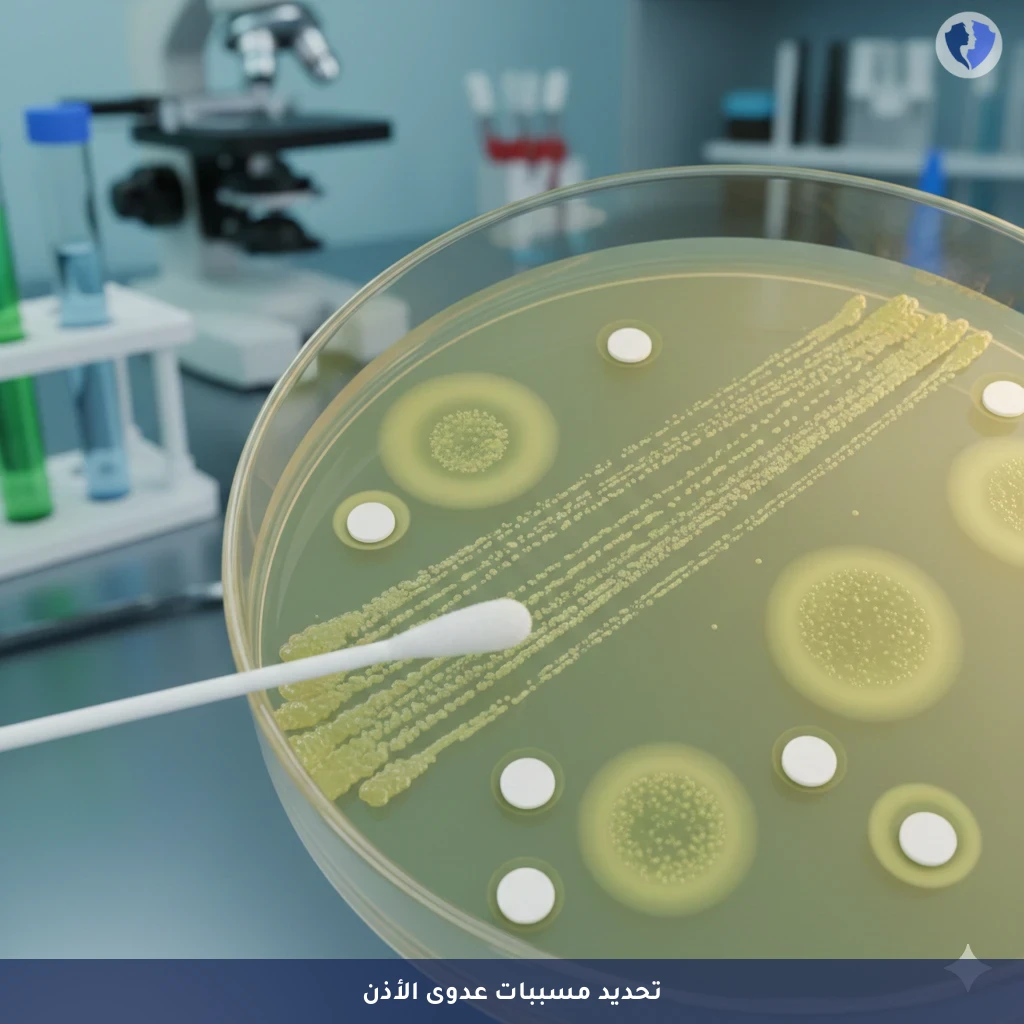
فحص شامل لالتهاب الأذن - مزرعة إفرازات الأذن اليمنى (Ear Discharge Culture - Right)

تفاصيل الخدمة
فحص شامل لالتهاب الأذن - مزرعة إفرازات الأذن اليمنى (Ear Discharge Culture - Right)
فحص ميكروبيولوجي يتم فيه زراعة عينة من إفرازات الأذن اليمنى على أوساط زرعية خاصة، لتحديد هوية الكائنات الحية الدقيقة (بكتيريا أو فطريات) المسببة للعدوى. يتضمن الاختبار أيضًا فحص الحساسية (Antibiotic Sensitivity) لتحديد المضادات الحيوية أو المضادات الفطرية الأكثر فعالية ضد العزلة الميكروبية المُكتشفة.